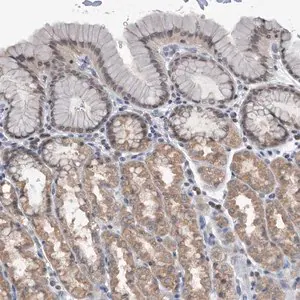
Merck Anti-TSTD1 antibody produced in rabbit

Merck Anti-TSTD1 antibody produced in rabbit
Rabbit에서 생산된 Anti-TSTD1 항체로 인간 시료에 반응합니다. Prestige Antibodies® Powered by Atlas Antibodies 제품이며, affinity isolated 형태입니다. 면역블롯팅 및 면역조직화학에 적합하며 −20°C에서 보관합니다.
✨AI 추천 연관 상품
AI가 분석한 이 상품과 연관된 추천 상품들을 확인해보세요
연관 상품을 찾고 있습니다...
Anti-TSTD1 antibody produced in rabbit
제품 개요
Prestige Antibodies® Powered by Atlas Antibodies, affinity isolated antibody, buffered aqueous glycerol solution
관련 항체
Anti-KAT, Anti-OR6-8, Anti-dJ80I19.4, Anti-thiosulfate sulfurtransferase (rhodanese)-like domain containing 1, Anti-hs6M1-6
생물학적 정보
| 항목 | 내용 |
|---|---|
| 생물학적 소스 | Rabbit |
| Quality Level | 100 |
| 결합 | Unconjugated |
| 항체 형태 | Affinity isolated antibody |
| 항체 유형 | Primary antibodies |
| 클론 | Polyclonal |
| 제품 라인 | Prestige Antibodies® Powered by Atlas Antibodies |
| 형태 | Buffered aqueous glycerol solution |
| Species reactivity | Human |
| 포장 | Antibody small pack of 25 μL |
| Technique(s) | Immunoblotting: 0.04–0.4 μg/mL Immunohistochemistry: 1:50–1:200 |
| 면역원 서열 | MAGAPTVSLPELRSLLASGRARLFDVRSREEAAAGTIPGALNIPVSELESALQMEPAAFQALYSAEKPKLEDEHLVFFCQMGKRGLQATQLARSLGYTGYG |
| UniProt 수납 번호 | Q8NFU3 |
| 배송 상태 | Wet ice |
| 저장 온도 | −20°C |
| Gene Information | Human TSTD1(100131187) |
제품 설명
TSTD1 (thiosulfate sulfurtransferase (rhodanese)-like domain containing 1)은 포유류에서 고도로 보존된 단백질로, 분자량은 약 12.5 kDa입니다. 신장, 간, 골격근, 심장, 대장, 흉선, 비장, 태반, 폐 등 다양한 인체 조직에서 발현되며, 주로 핵막 주변에 위치합니다. 또한 유방, 대장, 폐 암세포주에서도 발현이 보고되었으며, 종양 발생 과정에서 역할을 할 가능성이 제시되었습니다.
🏷️Merck Sigma 상품 둘러보기
동일 브랜드의 다른 상품들을 확인해보세요

Merck Sigma
Merck Anti-CEP104 antibody produced in rabbit
920,800원

Merck Sigma
Merck Anti-MYRIP antibody produced in rabbit

Merck Sigma
Merck Anti-TSTD1 antibody produced in rabbit
920,800원

Merck Sigma
Merck Anti-CELF3 antibody produced in rabbit
920,800원

Merck Sigma
Merck Anti-USP33 antibody produced in rabbit
920,800원
배송/결제/교환/반품 안내
배송 정보
| 기본 배송비 |
| 교환/반품 배송비 |
|
|---|---|---|---|
| 착불 배송비 |
| ||
| 교환/반품 배송비 |
| ||
결제 및 환불 안내
| 결제수단 |
|
|---|---|
| 취소 |
|
| 반품 |
|
| 환급 |
|
교환 및 반품 접수
| 교환 및 반품 접수 기한 |
|
|---|---|
| 교환 및 반품 접수가 가능한 경우 |
|
| 교환 및 반품 접수가 불가능한 경우 |
|
교환 및 반품 신청
| 교환 절차 |
|
|---|---|
| 반품 절차 |
|